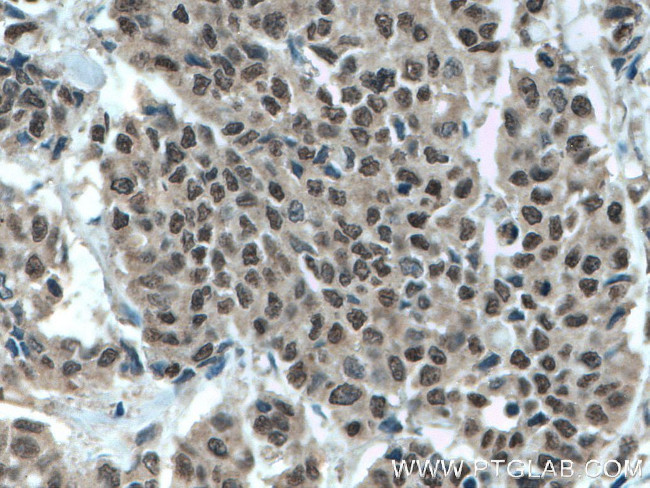
MLF1 Antibody in Immunohistochemistry (Paraffin) (IHC (P))

Search
Proteintech
MLF1 Polyclonal Antibody
{{$productOrderCtrl.translations['antibody.pdp.commerceCard.promotion.promotions']}}
{{$productOrderCtrl.translations['antibody.pdp.commerceCard.promotion.viewpromo']}}
{{$productOrderCtrl.translations['antibody.pdp.commerceCard.promotion.promocode']}}: {{promo.promoCode}} {{promo.promoTitle}} {{promo.promoDescription}}. {{$productOrderCtrl.translations['antibody.pdp.commerceCard.promotion.learnmore']}}
产品信息
13100-1-AP
种属反应
宿主/亚型
分类
类型
抗原
偶联物
形式
浓度
规格
纯化类型
保存液
内含物
保存条件
运输条件
产品详细信息
Immunogen sequence: MFRMLNSSF EDDPFFSESI LAHRENMRQM IRSFSEPFGR DLLSISDGRG RAHNRRGHND GEDSLTHTDV SSFQTMDQMV SNMRNYMQKL ERNFGQLSVD PNGHSFCSSS VMTYSKIGDE PPKVFQASTQ TRRAPGGIKE TRKAMRDSDS GLEKMAIGHH IHDRAHVIKK SKNKKTGDEE VNQEFINMNE SDAHAFDEEW QSEVLKYKPG RHNLGNTRMR SVGHENPGSR ELKRREKPQQ SPAIEHGRRS NVLGDKLHIK GSSVKSNKK (1-268 aa encoded by BC007045 )
靶标信息
SERBP1 may play a role in the regulation of mRNA stability. It binds to the 3'-most 134 nt of the SERPINE1/PAI1 mRNA, a region which confers cyclic nucleotide regulation of message decay.
仅用于科研。不用于诊断过程。未经明确授权不得转售。
生物信息学
蛋白别名: Hematopoietic lineage switch 7; MLF-1; Myelodysplasia-myeloid leukemia factor 1; Myeloid leukemia factor 1; t(3;5)(q25.1;p34) fusion gene; testis tissue sperm-binding protein Li 49e; unnamed protein product
基因别名: HLS7; MLF1
UniProt ID: (Human) P58340, (Mouse) Q9QWV4
Entrez Gene ID: (Human) 4291, (Mouse) 17349